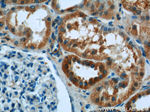
Syntaxin 17 Antibody in Immunohistochemistry (Paraffin) (IHC (P))

Search
Proteintech
Syntaxin 17 Polyclonal Antibody
{{$productOrderCtrl.translations['antibody.pdp.commerceCard.promotion.promotions']}}
{{$productOrderCtrl.translations['antibody.pdp.commerceCard.promotion.viewpromo']}}
{{$productOrderCtrl.translations['antibody.pdp.commerceCard.promotion.promocode']}}: {{promo.promoCode}} {{promo.promoTitle}} {{promo.promoDescription}}. {{$productOrderCtrl.translations['antibody.pdp.commerceCard.promotion.learnmore']}}
产品信息
17815-1-AP
种属反应
已发表种属
宿主/亚型
分类
类型
抗原
偶联物
形式
浓度
规格
纯化类型
保存液
内含物
保存条件
运输条件
产品详细信息
Immunogen sequence: MSEDEEKVK LRRLEPAIQK FIKIVIPTDL ERLRKHQINI EKYQRCGIWD KLHEEHINAG RTVQQLRSNI REIEKLCLKV RKDDLVLLKR MIDPVKEEAS AATAEFLQLH LESVEELKKQ FNDEETLLQP PLTRSMTVGG AFHTTEAEAS SQSLTQIYAL PEIPQDQNAA ESWETLEADL IELSQLVTDF SLLVNSQQEK IDSIADHVNS AAVNVEE (1-216 aa encoded by BC111009)
靶标信息
SNAREs, soluble N-ethylmaleimide-sensitive factor-attachment protein receptors, are essential proteins for fusion of cellular membranes. SNAREs localized on opposing membranes assemble to form a trans-SNARE complex, an extended, parallel four alpha-helical bundle that drives membrane fusion. STX17 is a SNARE of the autophagosome involved in autophagy through the direct control of autophagosome membrane fusion with the lysosome membrane. STX17 may also play a role in the early secretory pathway where it may maintain the architecture of the endoplasmic reticulum-Golgi intermediate compartment/ERGIC and Golgi and/or regulate transport between the endoplasmic reticulum, the ERGIC and the Golgi. (Uniprot)
仅用于科研。不用于诊断过程。未经明确授权不得转售。
生物信息学
蛋白别名: Syntaxin-17; unnamed protein product
基因别名: 4833418L03Rik; 6330411F21Rik; 9030425C21Rik; AW048351; STX17
UniProt ID: (Human) P56962, (Rat) Q9Z158, (Mouse) Q9D0I4
Entrez Gene ID: (Human) 55014, (Rat) 252853, (Mouse) 67727